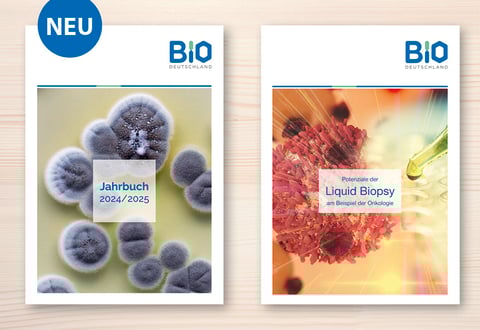

Bio Deutschland
Jahrbücher und Broschüren
BIO Deutschland fördert als Branchenverband der Biotechnologie-Industrie die Entwicklung eines innovativen Wirtschaftszweiges auf Basis der modernen Biowissenschaften.
Die Jahrbücher und Broschüren umfassen ca. 60-120 Seiten.
Broschüre Novel Food
Die kleine A5-Broschüre informiert über aktuelle Food-Trends und über nachhaltige und CO2-reduzierte Ernährungsformen der Zukunft.
Deutsche Biotechnologietage (DBT)
Die Deutschen Biotechnologietage sind ein jährlich stattfindender Fachkongress der Biotechnologie mit mehreren tausend Teilnehmern (Fotos: S. Kurc).
100 Jahre Biotechnologie
Für das Jubiläumsjahr 2019 "100 Jahre Biotechnologie" entwickelte Grafikrabe ein Projektlogo und das Projektdesign, das für verschiedene Materialien und Veranstaltungen Anwendung fand.

Infosäule (4x 1 x 3 m)
Infowand (6 x 2,5 m)